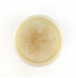
Комплект картриджів Raifil UF-11+IL10W-C BOX

- Опис
- Відгуки (0)
- Витр. матеріали
Raifil UF-11+IL10W-C BOX - це комплект, що складається з капілярної мембрани Raifil UF-11 і постфільтра Raifil IL-10W-C. У комплект також входять фітинги для підключення мембрани та постфільтра. Капілярна (ультрафільтраційна) мембрана виготовлена з харчового непрозорого пластику і спеціального трубчастого композиту всередині корпусу, який є фільтруючим матеріалом.
Ультрафільтраційна мембрана Raifil UF-11 встановлена у проточному фільтрі Raifil NOVO5, четвертим ступенем очищення води (тонке очищення). Завдяки мембрані Райфіл, вода, проходячи через неї, очищається від дрібних нерозчинних частинок, а також від великих мікробіологічних організмів присутніх у воді. Постфільтр Raifil IL-10W-C встановлений на проточному фільтрі Raifil NOVO5 п'ятим ступенем очищення води.
Технічні характеристики:
Розмір мембрани: 11"x2,5"
Розмір постфільтру: 10х2,5"![]() Робоча температура: 5-40 °C
Робоча температура: 5-40 °C
Робочий тиск: 3 - 6 бар
Виробник: Raifil